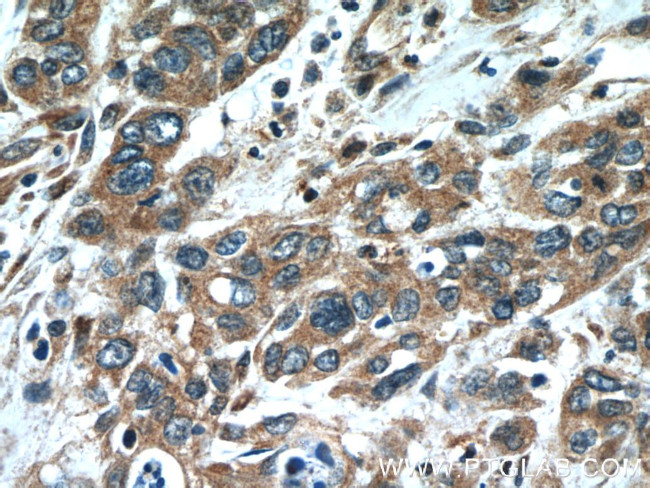
Oligophrenin 1 Antibody in Immunohistochemistry (Paraffin) (IHC (P))

Search
Proteintech
Oligophrenin 1 Polyclonal Antibody
{{$productOrderCtrl.translations['antibody.pdp.commerceCard.promotion.promotions']}}
{{$productOrderCtrl.translations['antibody.pdp.commerceCard.promotion.viewpromo']}}
{{$productOrderCtrl.translations['antibody.pdp.commerceCard.promotion.promocode']}}: {{promo.promoCode}} {{promo.promoTitle}} {{promo.promoDescription}}. {{$productOrderCtrl.translations['antibody.pdp.commerceCard.promotion.learnmore']}}
产品信息
17445-1-AP
种属反应
宿主/亚型
分类
类型
抗原
偶联物
形式
浓度
规格
纯化类型
保存液
内含物
保存条件
运输条件
产品详细信息
Immunogen sequence: MGHPPLEFS DCYLDSPDFR ERLKCYEQEL ERTNKFIKDV IKDGNALISA MRNYSSAVQK FSQTLQSFQF DFIGDTLTDD EINIAESFKE FAELLNEVEN ERMMMVHNAS DLLIKPLENF RKEQIGFTKE RKKKFEKDGE RFYSLLDRHL HLSSKKKESQ LQEADLQVDK ERHNFFESSL DYVYQIQEVQ ESKKFNIVEP VLAFLHSLFI SNSLTVELTQ DFLPYKQQLQ LSLQNTRNHF SSTREEMEEL KKRMKEAPQT CKLPGQPTIE GYLYTQEKCV WGHRGIHWVS ISQELLPLVG CEFWAPLLFI DP (1-311 aa encoded by BC059393)
靶标信息
Stimulates GTP hydrolysis of members of the Rho family. Its action on RHOA activity and signaling is implicated in growth and stabilization of dendritic spines, and therefore in synaptic function. Critical for the stabilization of AMPA receptors at postsynaptic sites. Critical for the regulation of synaptic vesicle endocytosis at presynaptic terminals. Required for the localization of NR1D1 to dendrites, can suppress its repressor activity and protect it from proteasomal degradation.
仅用于科研。不用于诊断过程。未经明确授权不得转售。
生物信息学
蛋白别名: Oligophrenin-1; oligophrenin-1, Rho-GTPase activating protein; unnamed protein product
基因别名: ARHGAP41; C130037N19Rik; MRX60; MRXSBL; OPHN1; OPN1
UniProt ID: (Human) O60890, (Rat) P0CAX5, (Mouse) Q99J31
Entrez Gene ID: (Human) 4983, (Rat) 312108, (Mouse) 94190